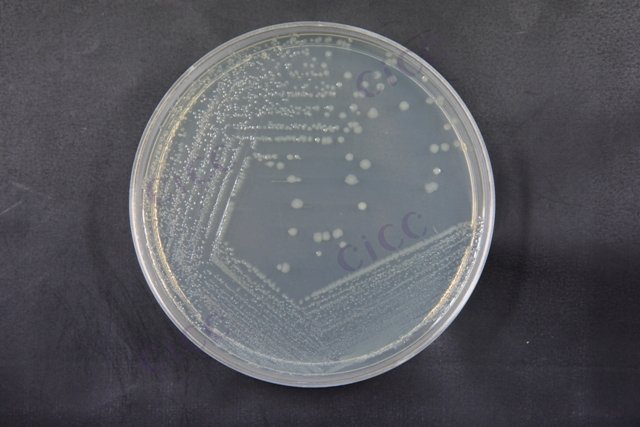
大肠埃希氏菌 Escherichia coli CICC 10305 Escherichia coli

大肠埃希氏菌 Escherichia coli CICC 10305 Escherichia coli
-
大肠埃希氏菌 Escherichia coli CICC 10300 Escherichia coli
CICC 10300 | 见证书
-
大肠埃希氏菌 Escherichia coli CICC 10302 Escherichia coli
CICC 10302 | 见证书
-
大肠埃希氏菌 Escherichia coli CICC 10303 Escherichia coli
CICC 10303 | 见证书
-
大肠埃希氏菌 Escherichia coli CICC 10304 Escherichia coli
CICC 10304 | 见证书
-
大肠埃希氏菌 Escherichia coli CICC 10308 Escherichia coli
CICC 10308 | 见证书
-
大肠埃希氏菌 Escherichia coli CICC 10375 Escherichia coli
CICC 10375 | 见证书
-
大肠埃希氏菌 Escherichia coli CICC 10047 Escherichia coli
CICC 10047 | 见证书

说明书下载: 菌种说明书 打管说明书
您正在浏览的产品:大肠埃希氏菌 Escherichia coli CICC 10305
手机版:大肠埃希氏菌 Escherichia coli CICC 10305
本公司销售的所有产品仅供实验科研使用,不用于人体及临床诊断。
2. 选择性增菌:接种EC肉汤44℃培养24小时
3. 分离培养:CT-SMAC平板筛选可疑菌落
4. 生化鉴定:IMViC系列试验
5. 血清学试验:O157:H7特异性抗原检测
6. 分子确认:stx1/stx2毒素基因PCR检测[3][5][8]
2. O157:H7检测需在生物安全二级实验室操作
3. 冷冻样品需在45℃水浴中快速解冻
4. 阳性结果需经省级疾控中心复核确认[3][5][8]
以上信息仅供参考,请以相应标准的原文为准!